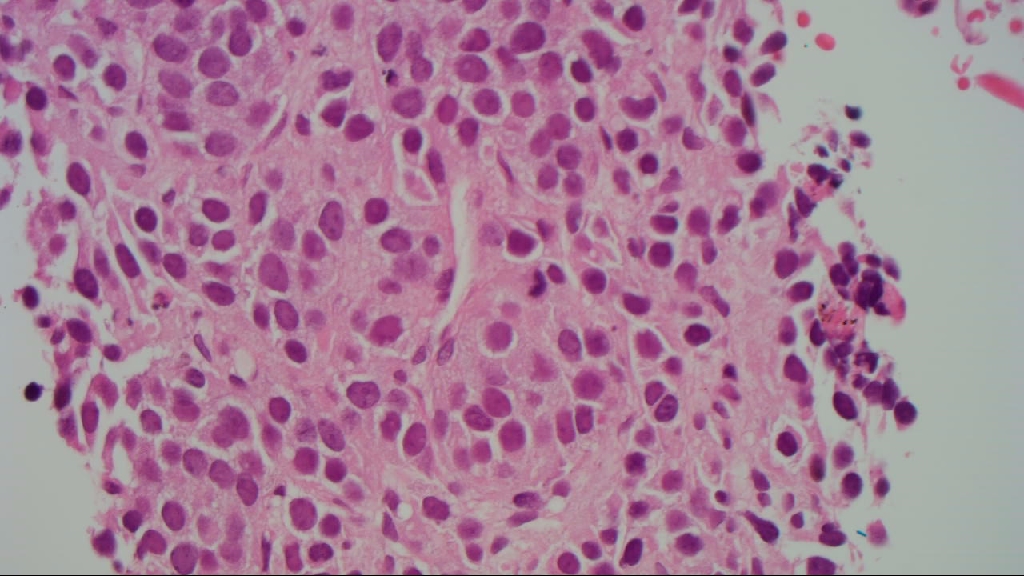

06/10/2016 12:01 AM Suffix - Tissue Types HN001615E/16
1 - EBUS Endo-Bronchial Sample 2 - EBUS Endo-Bronchial Sample
3 - EBUS Endo-Bronchial Sample
Report sequence 1 Authorised 12/10/2016 11:01
By Dr T Bracey CELLPATH (Tim's laptop)
NATURE OF SPECIMEN: 2 WW.
EBUS transbronchial lymph node aspirates.
CLINICAL DETAILS:
EBUS samples from the following nodes: 4R, 4L, 7.
Indication: LLL lesion with mediastinal lymphadenopathy.
General findings: Normal endoscopic examination to the limit of the scope vision.
Systematic lymph node examination. Nil to see at 11L and 11R.
4R - 1.2cm heterogeneous node - 4 passes. Soft little return and likely necrotic.
4L - 1.5cm very necrotic looking node - 3 passes with little return.
7 - 1.8cm nodal cluster - 4 passes. Haemostasis achieved.
No immediate complications.
GROSS DESCRIPTION:
1. Moderate brown material - Station 4R
EBUS; N4
2. Scanty brown material - Station 4L
EBUS; N4
3. Moderate brown material - Station 7
EBUS; N4
CYTOLOGICAL REPORT:
1. Dissociated fragments of tumour with mild pleomorphism, round to oval nuclei and nucleoli are not easily seen. There are occasional mitotic figures and focal punctate necrosis but there is insufficient material for a formal mitotic count/grading.
2. Scanty fragments of cohesive tumour cells with a packeted architecture and minimal nuclear pleomorphism. A single mitotic figure is identified but there is insufficient material for a formal mitotic count. The tumour cells are immunopositive for MNF116 (with paranuclear accentuation), diffuse nuclear TTF 1, chromogranin, and the MIB-1 proliferation index is 16%.
3. Blood clot and scanty fragments of anthracotic lymph node.
Conclusion
1-3. EBUS samples - neuroendocrine tumour in specimens 1 and 2 (see text).
Comment: Please correlate with the clinical impression. Sampling is insufficient for formal grading but the clinical distribution of tumour and the presence of punctate necrosis and mitotic figures aludes to at least atypical carcinoid tumour.
Reported by: Dr Tim Bracey using speech recognition
insular/packeted architecture |
TTF 1 positive |

chromogranin |

proliferation 16% |
